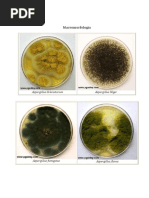
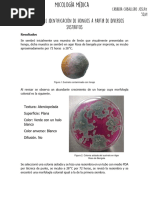
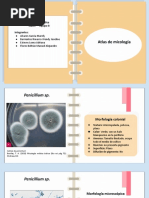

100% encontró este documento útil (6 votos)
5K vistas2 páginasPenicillium SP
Este documento describe la identificación de un hongo del género Penicillium aislado de un ajo. Presenta las características morfológicas coloniales y microscópicas del hongo, incluyendo su micelio macrosifonado, conidióforos, fiálides y microconidios. Además, discute la importancia de algunas especies de Penicillium, como P. chrysogenum que produce la penicilina, y su uso en la elaboración de quesos.
Cargado por
DanaisDerechos de autor
© © All Rights Reserved
Nos tomamos en serio los derechos de los contenidos. Si sospechas que se trata de tu contenido, reclámalo aquí.
Formatos disponibles
Descarga como DOCX, PDF, TXT o lee en línea desde Scribd
100% encontró este documento útil (6 votos)
5K vistas2 páginasPenicillium SP
Este documento describe la identificación de un hongo del género Penicillium aislado de un ajo. Presenta las características morfológicas coloniales y microscópicas del hongo, incluyendo su micelio macrosifonado, conidióforos, fiálides y microconidios. Además, discute la importancia de algunas especies de Penicillium, como P. chrysogenum que produce la penicilina, y su uso en la elaboración de quesos.
Cargado por
DanaisDerechos de autor
© © All Rights Reserved
Nos tomamos en serio los derechos de los contenidos. Si sospechas que se trata de tu contenido, reclámalo aquí.
Formatos disponibles
Descarga como DOCX, PDF, TXT o lee en línea desde Scribd